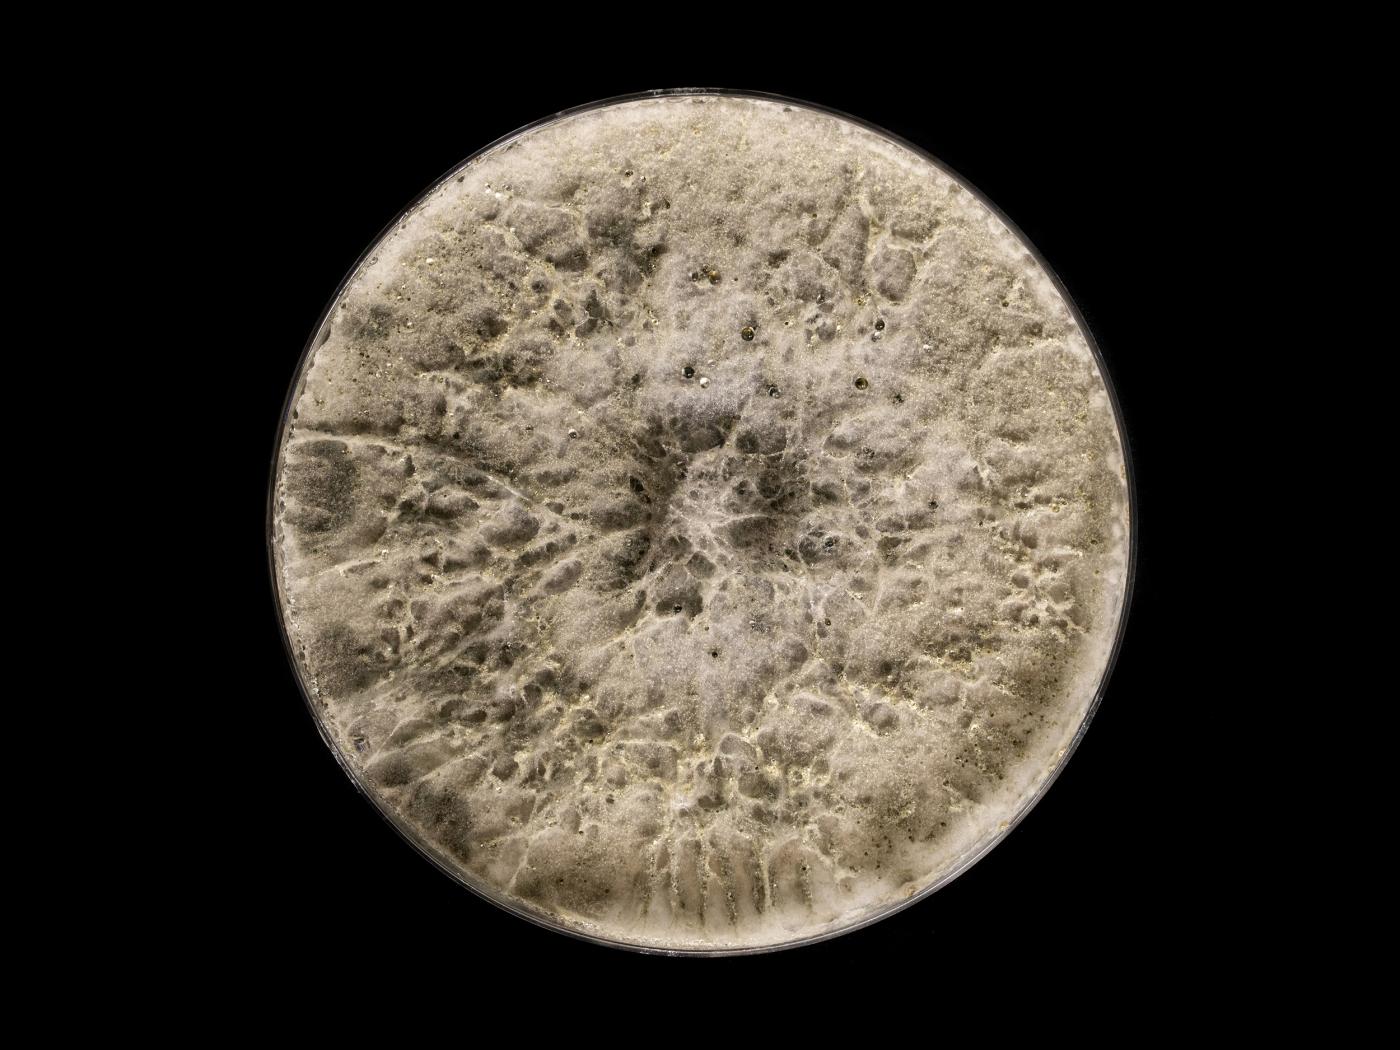

Nom latin :
Botryosphaeria dothidea
Nom latin synonyme :
Fusicoccum aesculi
Cultures ou autres organismes affectés
Bleuet en corymbe
/fr/maladies-parasitaires/champignons/botryosphaeria-dothidea/bleuet-en-corymbe-chancre-botryosphaeria
Bleuet en corymbe - Chancre à Botryosphaeria (Botryosphaeria dothidea)_1
Bleuet en corymbe - Chancre à Botryosphaeria (Botryosphaeria dothidea)_2
Bleuet en corymbe - Chancre à Botryosphaeria (Botryosphaeria dothidea)_3
Bleuet en corymbe - Chancre à Botryosphaeria (Botryosphaeria dothidea)_4
Bleuet en corymbe - Chancre à Botryosphaeria (Botryosphaeria dothidea)_5
Bleuet en corymbe - Chancre à Botryosphaeria (Botryosphaeria dothidea)_2
Bleuet en corymbe - Chancre à Botryosphaeria (Botryosphaeria dothidea)_3
Bleuet en corymbe - Chancre à Botryosphaeria (Botryosphaeria dothidea)_4
Bleuet en corymbe - Chancre à Botryosphaeria (Botryosphaeria dothidea)_5